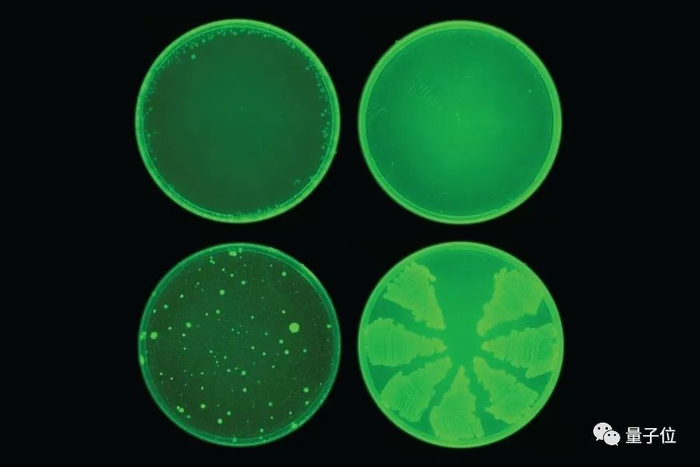

原标题:患上乳腺癌后开发AI诊断模型,这位MIT女科学家获得AAAI首届百万美元最高奖 来源:量子位
Original
杨净 贾浩楠 发自 凹非寺 量子位 报道 | 公众号 QbitAI
获奖者是来自MIT计算机与人工智能实验室(CSAIL)的Regina Barzilay教授。

获奖原因是,她开发了用来早期预警和防治乳腺癌、开发抗生素等药物的ML模型,获得了广泛的认可。
明年2月,AAAI将正式为她颁发这一奖项——AAAI Squirrel AI 奖,奖金高达100万美元。
AAAI前任主席兼奖励委员会主席Yolanda Gil表示:
只有世界知名的奖项,比如图灵奖、诺贝尔奖,才会获得百万级别的奖金。
该奖项旨在表彰那些在AI领域工作对人类、社会产生变革性影响的人。
那么这位首届「AI诺贝尔奖」得主,究竟有何厉害之处?
罹患癌症:从NLP转战医疗AI
Regina Barzilay,MIT电机工程与计算机科学系教授、CSAIL成员。
她曾在以色列内盖夫本古里安大学获得本科学位,随后前往哥伦比亚大学攻读计算机科学博士学位,并在康奈尔大学做了一年博士后研究。

Barzilay最早的研究领域并不是AI医疗,而主要是NLP(自然语言处理),从句法解析和破译灭绝语言,到开发新的方法来训练神经网络。
她在这个领域可以说是卓有成就,多次获ACL、EMNLP、SLT最佳论文奖,ACL、AAAI奖学金,以及美国国家科学基金会(NSF)职业奖、微软院士奖学金。
然而2014年的一次诊断改变了她的人生轨迹:她被诊断出患有乳腺癌。
当时,Barzilay的第一反应是:“我会活下来吗?我的儿子怎么办?”
但是作为一位AI领域的科学家,Barzilay又给自己提出了第三个问题:为什么乳腺癌不能更早早诊断出来呢?
根据JAMA(《美国医学会杂志》)统计,乳腺癌,作为女性最常见的癌症之一,也是死亡人数最高的。
幸运的是,她的治疗很成功。

在治疗过程中,她发现医疗团队在治疗护理方面已经做得很好了。
但与此同时,在技术上可以做到的,却连最简单的事情都没有解决,比如,诊断延迟、无法收集数据,以及用作诊断研究中的统计缺陷等。
也就是从那时开始,她开始关注乳腺癌早期防治医学上来。
她创建了早期乳腺癌诊断和风险评估的算法模型,该项目已经在全球多家医院,包括瑞典、波士顿、中国台湾地区等地方落地。
现在她正与巴西的Protea研究所等乳腺癌组织合作,为世界各地的贫困人口提供诊断工具。
她发现,如果当时使用自己这个系统,那么医生至少可以提前两三年发现她的癌症。
2018年,她正式成为「Susan Komen」基金会学者,一个由51位专家组成,专注于乳腺癌研究的美国规模最大的乳腺癌组织。
除了将AI技术用于诊断,她也致力于开发用ML模型来研发新的药物。
她跟合作者一起创建了用于选择治疗药物候选分子的模型,这些模型可以加快药物开发的速度。
很快,就在去年,她就发现了一种名为「Halicin」的抗生素。

实验证明,它能够杀死致病细菌,包括很多对抗生素有抗药性的细菌,比如,鲍曼不动杆菌(医院感染的重要病原菌、主要引起呼吸道感染)。
并由此,获得了2019年药物发现和医疗保健领域的前100名AI引领者(Top 100 AI Leaders in Drug Discovery & Advanced Healthcare 2019)。
作为J-Clinic共同负责人之一,最近专注于一个「AI Cures」的研究,这是一个跨机构的倡议,专注于开发负担得起的Covid-19抗病毒药物。
MIT CSAIL负责人Daniela Rus表示,
Regina一直是医疗AI领域的开拓者,她提出了关于我们如何使用机器学习来治疗和诊断疾病的重要问题。
她既是一位杰出的研究者,也是一位忠实的教育者,我们CSAIL的所有人都被她的工作所鼓舞,并为有她作为同事而感到自豪。
乳腺癌预警准确率提高13%
最值得一提的,就是她研发的早期乳腺癌诊断预警模型。
正如今天,MIT CSAIL在社交网络上表示,2014年她被诊断为乳腺癌,2017年,他建立了早期诊断风险评估模型,然后在今天,成为首届AI诺贝尔奖得主,也主要因为这项工作。

现在,她的这项研究——使用AI算法来判断癌症风险,已经投入临床了。
过去最常使用的的算法是Tyrer-Cuzick模型。
TC模型是在通用风险算法Gail上,结合了乳房造影密度和乳腺纤维腺体组织等乳腺癌风险因素的预警模型。

但是,TC模型有明显的缺陷。因为乳房造影密度是一个主观概念,不同的医师在操作时,对于机器给出的阴影密度数值会有不同的判断。
此外,TC算法考虑的因素不够全面,同一密度数值的患者,最终诊断结果可能完全不同。
而针对TC模型的不足,Barzilay博士和她的团队开发了三种不同的模型。
一种是基于传统风险因素进行判断的逻辑回归模型(RF-LR);将患者在进行乳房X光检查时的风险因素映射到患者在5年内是否患癌这个结果上。
第二个是仅基于X光片图像的深度学习模型;用PyTorch构建了一个深度卷积神经网络ResNet。给定一个乳房的1664 X 2048像素图片,模型会预测是否会在5年内发展成乳腺癌。
最后一种是结合RF-LR和X光片的混合模型,这也是最终投入临床使用,准确率最高的模型。
所有模型的训练数据,是团队从医疗机构获取的从2009年到2012年间,60886名患者的检查资料。其中既包括乳腺癌确诊,也有疑似乳腺癌,最后没有确诊的。
团队还对每名提供资料的患者进行为期5年的医学随访,以确认模型的准确率。
为了衡量模型捕获长期未来风险的能力,需要计算每种模型的AUC(接收器工作特性曲线下的面积),以区分3–5年内患癌症的患 者和5年内未患癌症的患者。

混合模型的取得较好预测成绩的一个重要原因,是判断癌症发病率并不是仅仅按照X光片的组织致密度,而是综合了从过往病历中学习到经验,包括年龄、病史、生理周期等等因素。
在临床对比中,在已确诊的乳腺癌患者中,混合模型在前期就对其中的31%作出了预警,而传统的TC模型的有效预警仅有18%。
目前这项技术已经在新加坡、中国台湾、美国、瑞典等等多家医院进行了测试。
第一届AI“诺贝尔奖”
颁出这个奖项的AAAI,大家已经很熟悉了,美国人工智能协会, 是人工智能领域的主要学术组织之一。
如今AAAI已经改名成了“人工智能促进协会”(the Association for the Advance of Artificial Intelligence)。
说到这个奖项,是由国内的AI教育企业松鼠AI和AAAI联合设置的,当然,100万美元的奖金,也是由松鼠AI出。
其实,奖项的全名,也冠上了“AAAI和松鼠AI人工智能人类福祉奖”(AAAI SQUIRREL AI AWARD FOR ARTIFICIAL INTELLIGENCE FOR THE BENEFIT OF HUMANITY)。
这个奖项,颁给”用有意义的方式保护,增强和改善人类生活,并具有长效影响的的人工智能进展。”
评奖委员会,也是AAAI的会员、学术界大佬,其中包括深度学习三巨头之一Bengio。

在AAAI官网上,并没有说这是“AI诺贝尔奖”,只是去年松鼠AI与AAAI达成合作后,在国内的宣传上,用了“AI诺贝尔奖”这个词。


获奖原因是,她开发了用来早期预警和防治乳腺癌、开发抗生素等药物的ML模型,获得了广泛的认可。
明年2月,AAAI将正式为她颁发这一奖项——AAAI Squirrel AI 奖,奖金高达100万美元。
AAAI前任主席兼奖励委员会主席Yolanda Gil表示:
只有世界知名的奖项,比如图灵奖、诺贝尔奖,才会获得百万级别的奖金。
该奖项旨在表彰那些在AI领域工作对人类、社会产生变革性影响的人。
那么这位首届「AI诺贝尔奖」得主,究竟有何厉害之处?
罹患癌症:从NLP转战医疗AI
Regina Barzilay,MIT电机工程与计算机科学系教授、CSAIL成员。
她曾在以色列内盖夫本古里安大学获得本科学位,随后前往哥伦比亚大学攻读计算机科学博士学位,并在康奈尔大学做了一年博士后研究。

Barzilay最早的研究领域并不是AI医疗,而主要是NLP(自然语言处理),从句法解析和破译灭绝语言,到开发新的方法来训练神经网络。
她在这个领域可以说是卓有成就,多次获ACL、EMNLP、SLT最佳论文奖,ACL、AAAI奖学金,以及美国国家科学基金会(NSF)职业奖、微软院士奖学金。
然而2014年的一次诊断改变了她的人生轨迹:她被诊断出患有乳腺癌。
当时,Barzilay的第一反应是:“我会活下来吗?我的儿子怎么办?”
但是作为一位AI领域的科学家,Barzilay又给自己提出了第三个问题:为什么乳腺癌不能更早早诊断出来呢?
根据JAMA(《美国医学会杂志》)统计,乳腺癌,作为女性最常见的癌症之一,也是死亡人数最高的。
幸运的是,她的治疗很成功。

在治疗过程中,她发现医疗团队在治疗护理方面已经做得很好了。
但与此同时,在技术上可以做到的,却连最简单的事情都没有解决,比如,诊断延迟、无法收集数据,以及用作诊断研究中的统计缺陷等。
也就是从那时开始,她开始关注乳腺癌早期防治医学上来。
她创建了早期乳腺癌诊断和风险评估的算法模型,该项目已经在全球多家医院,包括瑞典、波士顿、中国台湾地区等地方落地。
现在她正与巴西的Protea研究所等乳腺癌组织合作,为世界各地的贫困人口提供诊断工具。
她发现,如果当时使用自己这个系统,那么医生至少可以提前两三年发现她的癌症。
2018年,她正式成为「Susan Komen」基金会学者,一个由51位专家组成,专注于乳腺癌研究的美国规模最大的乳腺癌组织。
除了将AI技术用于诊断,她也致力于开发用ML模型来研发新的药物。
她跟合作者一起创建了用于选择治疗药物候选分子的模型,这些模型可以加快药物开发的速度。
很快,就在去年,她就发现了一种名为「Halicin」的抗生素。
实验证明,它能够杀死致病细菌,包括很多对抗生素有抗药性的细菌,比如,鲍曼不动杆菌(医院感染的重要病原菌、主要引起呼吸道感染)。
并由此,获得了2019年药物发现和医疗保健领域的前100名AI引领者(Top 100 AI Leaders in Drug Discovery & Advanced Healthcare 2019)。
作为J-Clinic共同负责人之一,最近专注于一个「AI Cures」的研究,这是一个跨机构的倡议,专注于开发负担得起的Covid-19抗病毒药物。
MIT CSAIL负责人Daniela Rus表示,
Regina一直是医疗AI领域的开拓者,她提出了关于我们如何使用机器学习来治疗和诊断疾病的重要问题。
她既是一位杰出的研究者,也是一位忠实的教育者,我们CSAIL的所有人都被她的工作所鼓舞,并为有她作为同事而感到自豪。
乳腺癌预警准确率提高13%
最值得一提的,就是她研发的早期乳腺癌诊断预警模型。
正如今天,MIT CSAIL在社交网络上表示,2014年她被诊断为乳腺癌,2017年,他建立了早期诊断风险评估模型,然后在今天,成为首届AI诺贝尔奖得主,也主要因为这项工作。

现在,她的这项研究——使用AI算法来判断癌症风险,已经投入临床了。
过去最常使用的的算法是Tyrer-Cuzick模型。
TC模型是在通用风险算法Gail上,结合了乳房造影密度和乳腺纤维腺体组织等乳腺癌风险因素的预警模型。

但是,TC模型有明显的缺陷。因为乳房造影密度是一个主观概念,不同的医师在操作时,对于机器给出的阴影密度数值会有不同的判断。
此外,TC算法考虑的因素不够全面,同一密度数值的患者,最终诊断结果可能完全不同。
而针对TC模型的不足,Barzilay博士和她的团队开发了三种不同的模型。
一种是基于传统风险因素进行判断的逻辑回归模型(RF-LR);将患者在进行乳房X光检查时的风险因素映射到患者在5年内是否患癌这个结果上。
第二个是仅基于X光片图像的深度学习模型;用PyTorch构建了一个深度卷积神经网络ResNet。给定一个乳房的1664 X 2048像素图片,模型会预测是否会在5年内发展成乳腺癌。
最后一种是结合RF-LR和X光片的混合模型,这也是最终投入临床使用,准确率最高的模型。
所有模型的训练数据,是团队从医疗机构获取的从2009年到2012年间,60886名患者的检查资料。其中既包括乳腺癌确诊,也有疑似乳腺癌,最后没有确诊的。
团队还对每名提供资料的患者进行为期5年的医学随访,以确认模型的准确率。
为了衡量模型捕获长期未来风险的能力,需要计算每种模型的AUC(接收器工作特性曲线下的面积),以区分3–5年内患癌症的患 者和5年内未患癌症的患者。

混合模型的取得较好预测成绩的一个重要原因,是判断癌症发病率并不是仅仅按照X光片的组织致密度,而是综合了从过往病历中学习到经验,包括年龄、病史、生理周期等等因素。
在临床对比中,在已确诊的乳腺癌患者中,混合模型在前期就对其中的31%作出了预警,而传统的TC模型的有效预警仅有18%。
目前这项技术已经在新加坡、中国台湾、美国、瑞典等等多家医院进行了测试。
第一届AI“诺贝尔奖”
颁出这个奖项的AAAI,大家已经很熟悉了,美国人工智能协会, 是人工智能领域的主要学术组织之一。
如今AAAI已经改名成了“人工智能促进协会”(the Association for the Advance of Artificial Intelligence)。
说到这个奖项,是由国内的AI教育企业松鼠AI和AAAI联合设置的,当然,100万美元的奖金,也是由松鼠AI出。
其实,奖项的全名,也冠上了“AAAI和松鼠AI人工智能人类福祉奖”(AAAI SQUIRREL AI AWARD FOR ARTIFICIAL INTELLIGENCE FOR THE BENEFIT OF HUMANITY)。
这个奖项,颁给”用有意义的方式保护,增强和改善人类生活,并具有长效影响的的人工智能进展。”
评奖委员会,也是AAAI的会员、学术界大佬,其中包括深度学习三巨头之一Bengio。

在AAAI官网上,并没有说这是“AI诺贝尔奖”,只是去年松鼠AI与AAAI达成合作后,在国内的宣传上,用了“AI诺贝尔奖”这个词。
△图源:中国网
“AI诺贝尔奖”是为了宣传,没有被广泛认可,甚至AAAI官网也没有这么说,但每年拿出100万美金的真金白银,确实没有假。
从获奖的Regina Barzilay博士来说,不幸罹患癌症,却能从中发现科研课题,并且坚持用几年时间持续研究,用AI将乳腺癌诊疗技术向前带动了重要一步,也为全世界无数女性患者,带来了更多先期发现治疗的希望。
从人道主义角度考察,Barzilay博士获得这个奖实至名归。
至于松鼠AI,算是用力所能及的方式为人工智能的发展做出了努力吧~
参考链接:
https://news.mit.edu/2020/regina-barzilay-wins-aaai-squirrel-ai-award-artificial-intelligence-0923
https://jclinic3.wixsite.com/reginabarzilay
https://news.mit.edu/2017/mit-computer-scientist-regina-barzilay-wins-macarthur-genius-grant-1011
https://www.medsci.cn/article/show_article.do?id=a0a8180225a9
http://edu.china.com.cn/2019-05/28/content_74830081.htm


